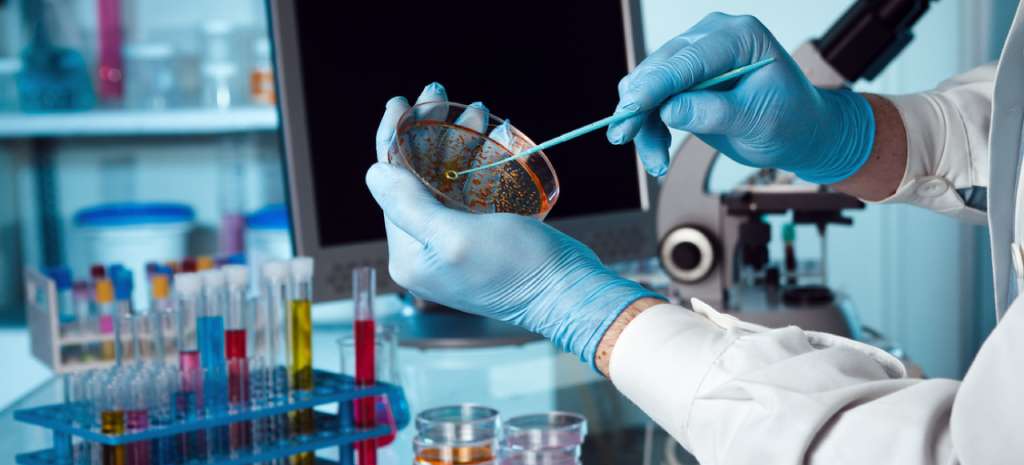

Этапы проведения и предварительные материалы ОВОС
Этапы проведения и предварительные материалы ОВОС
23 ноября 2023
Содержание статьи:
Время прочтения: 4 минуты.
ОВОС – оценка воздействия на окружающую среду в результате которой оценивается возможный ущерб, который может причинить природе реализация строительного проекта. Это сложная многоступенчатая процедура, задача которой – проанализировать все аспекты будущего строительства, не допустить чрезмерного негативного влияния на природу и ухудшения качества жизни населения ближайших городов и поселков. У процедуры ОВОС достаточно сложная структура, поэтому оценка может занимать много времени.
Этапы процедуры овос
Последовательность этапов процедуры ОВОС установлена федеральным законодательством. Она предполагает всесторонний независимый анализ проектной документации, по результатам которого собранные материалы будут переданы на государственную экологическую экспертизу (ГЭЭ).
Можно перечислить следующие этапы процедуры ОВОС:
- Подготовка уведомления, предварительная оценка и подготовка технического задания. Заказчик должен подготовить базовую информацию об объекте и уведомить органы власти о предстоящем строительстве. На этом этапе необходимо убедить государственные органы и общественность в обоснованности и целесообразности будущего строительства, а также в его безопасности для окружающей среды и населения.
- На втором этапе подготавливается ЗВОС – заявление о воздействии на окружающую среду. Для его подготовки необходимо проанализировать текущее состояние окружающей среды, в том числе биологические, геологические, гидрологические и другие факторы. Проводится всесторонняя оценка будущего объекта на компоненты природной среды: почву, воздух, водоемы и т. д. На основе собранных данных подготавливается экспертная оценка, разрабатывается прогноз будущего воздействия объекта на окружающую среду.
- На следующем этапе организуются общественные слушания. Информация о проекте размещается в свободном доступе, организуются общественные приемные для ознакомления с материалами. В ходе слушаний выявляются возможные негативные стороны строительства, по мере необходимости в проект будут внесены корректировки.
- На завершающем этапе подготавливается окончательная версия проекта с учетом результатов общественных обсуждений.
Что такое предварительные материалы ОВОС?
Предварительные материалы ОВОС – это основная информация о будущем объекте строительства. Порядок подготовки таких материалов установлен пунктами 4.4-4.5 Приказа Минприроды России от 01 декабря 2020 года № 999.
Уведомление и предварительная оценка
В ходе предварительной оценки собираются материалы о будущем объекте строительства. Это информация о предприятии и о компонентах окружающей среды, на которые может быть оказано негативное влияние в ходе его строительства и эксплуатации. Оценивается будущее воздействие на различные компоненты природной среды:
- На атмосферу;
- На природные водоемы и подземные воды;
- На почву;
- На растения и животных.
Также необходимо провести оценку возможного негативного влияния физических факторов: повышенного шумового и вибрационного воздействия, электромагнитного и радиационного излучения. Конкретное содержание предварительных материалов будет зависеть от специфики объекта и направления его работы.
Кому нужны предварительные материалы ОВОС?
Подготовка предварительных материалов требуется всем объектам, для которых проводится ОВОС. Обычно она требуется тем предприятиям, для которых обязательно прохождение Государственной экологической экспертизы (ГЭЭ).
Проведение исследований и подготовка предварительных заключений
В ходе исследований оценивается, как будет влиять новый промышленный или иной объект на различные компоненты биосферы. При составлении прогнозов учитываются промышленные выбросы, сбросы загрязняющих веществ в водоемы, образование отходов производства и потребления, а также другие факторы, способные негативно повлиять на состояние окружающей среды.
По результатам проведенных исследований подготавливаются предварительные заключения. Они должны пройти обсуждение в экспертном сообществе и среди представителей различных групп населения. Только после этого проект сможет перейти на следующий этап согласования.

Правильное составление ТЗ для ОВОС
Одним из этапов проведения ОВОС является правильное составление ТЗ заказчиком для исполнителя. В техническом задании отображаются все требования к проведению исследования: но должно охватывать все виды возможного негативного влияния на окружающую среду. При подготовке ТЗ учитывается специфика будущего объекта, его предполагаемое расположение, специфика деятельности, возможные негативные факторы влияния на окружающую среду.
Информирование госорганов и общественности
Одним из обязательных требований при проведении ОВОС является уведомление государственных органов о предстоящем строительстве и организация общественных обсуждений. Проектная документация размещается в свободном доступе – ознакомиться с ней может любой желающий. Регламент проведения общественных слушаний установлен в «Положении об оценке воздействия намечаемой хозяйственной и иной деятельности на окружающую среду в Российской Федерации».
Общественные обсуждения, как правило, становятся особенно сложными перед строительством мусороперерабатывающих предприятий и других объектов, которые оказывают существенное воздействие на окружающую среду. У реализации таких проектов много противников, поэтому необходимо строго следить за соблюдением регламента обсуждений, фиксировать предложения и искать компромиссные решения, которые не позволят остановить строительство.
Результаты общественных обсуждений фиксируются в протоколе, вынесенные предложения должны использоваться для доработки проектной документации. Может быть принято решение перенести строительство на другую площадку, могут быть внесены изменения в проектную документацию.
Окончательное составление документации
Завершающим этапом является составление окончательного варианта проекта. При этом учитываются все результаты проведенных экспертиз и обсуждений, на данном этапе подготавливается заключительный комплект материалов.
Передача ОВОС на государственную экспертизу
Подготовленный комплект документации передается на ГЭЭ – государственную экологическую экспертизу, которая должна подтвердить обоснованность строительства или вынести отрицательное решение. Для получения положительного заключения ГЭЭ необходимо доказать, что реализация строительного проекта и дальнейшая работа предприятия не приведут к существенному ухудшению экологической обстановки.
Прохождение всех этапов ОВОС требует достаточно много времени и обработки больших объемов информации. Воспользуйтесь услугами компании «ЭкоРазвитие», чтобы успешно пройти через эту процедуру и получить положительное заключение ГЭЭ. Наши эксперты помогут собрать данные, проведут комплексный анализ, помогут организовать все этапы обсуждений и окончательной доработки проекта перед его подачей на экспертизу.
Предоставляем эту услугу
Можете почитать о ней подробнее ли пообщаться с нашими специалистами напрямую в месседжерах
Оставить заявку
Ваше имя:
Ваш телефон:
Услуга:
Не выбрано
Нажимая на кнопку Отправить, вы соглашаетесь с политикой конфиденциальности
ОСТАВАЙТЕСЬ НА СВЯЗИ
620026, г. Екатеринбург , ул. Декабристов, д. 14, офис 204, БЦ "Альянс" (Вход в здание по паспорту)


